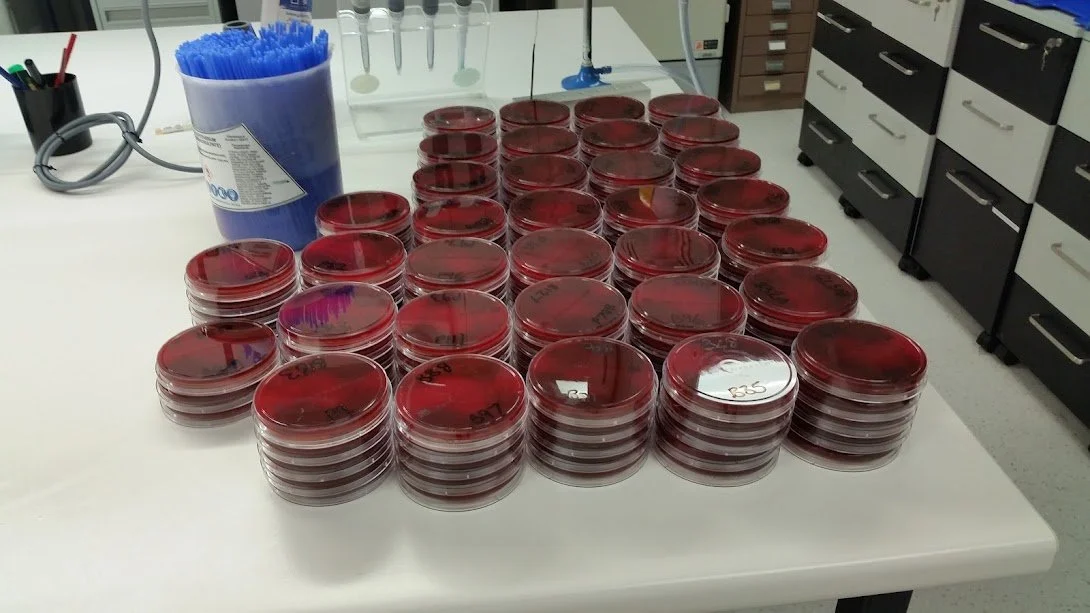

About the Founder
David Wakeham
David Wakeham, the founder of DW Tutoring is a dedicated STEM educator and mentor with a PhD (ABD) in veterinary microbiology, epidemiology, and bioinformatics. With over 15 years of teaching and research experience, they have specialised in using whole genome sequencing and bioinformatics to study zoonotic and antimicrobial-resistant bacteria in livestock and companion animals. Their work has contributed to advancing knowledge in animal health and has been shared through publications, presentations, and NFP volunteering outreach activities.
As multiply disabled and neurodivergent individual, they are passionate about creating accessible and inclusive learning environments. Drawing on their experiences and ongoing Master of Education studies, which focus on Indigenous teaching pedagogies, creative learning, and inclusive approaches for students with learning difficulties, they bring a unique perspective to their role as founder and head tutor of DW Tutoring.
This personalised tutoring service is designed to support neurodiverse and disabled students at all educational levels, from foundation to postgraduate studies. In addition to their professional expertise, the founder is a multilingual communicator with basic proficiency in Vietnamese, Italian, and French. They are also an avid writer, particularly of poetry, which they often incorporate into tutoring sessions as a creative teaching tool.
Their diverse interests include animal behaviour, baking, bushwalking, music (especially the Blues), classical literature, art history, theatre, and more. These passions reflect their holistic approach to education, which aims to teach and inspire lifelong curiosity and learning in their students.